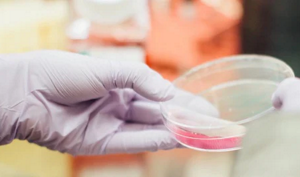

- Home
- Fragrance Palette

Fragrance Palette
There are nearly 4,000 raw materials available to develop fragrances. Actual fragrance formulas can be quite complex, typically including 10 – 200 individual raw materials, even though fragrance is commonly present at 1% or less in personal care products.
The vast majority of these fragrance materials are safe for consumers to use. However, as with so many things in our world, there are a small number that may not be suited for all consumers. Some people have allergies which are an immune response when exposed to a material.
Other people that have not developed an allergy will have no response. Governmental Regulatory Bodies, IFRA, and personal care product manufacturers closely monitor developments in the marketplace and scientific research to identify if a fragrance material should either be completely avoided or used below specific levels that would reduce the probability of allergies developing.
We have developed a Fragrance Palette guide for creating our new products. This guide includes a list of safe materials and concentration restrictions imposed by Governmental Regulatory Agencies or IFRA. This list is updated based on the latest safety data and represents all ingredients that could be used in creating our fragrances. We share this information with you as “Fragrance Palette.”
To further inform our consumers, our scientists have identified a list of materials that will not be included in our fragrances. This list is shared with fragrance suppliers to ensure that these materials are not used in the development of the products we make. This list goes above and beyond what is required by regulations and IFRA. As consumer safety is one of our core guiding principles, we often choose to take a more conservative approach. We share this information with you as our “Disallowed Materials List.” As soon as an item is placed on the “Disallowed Materials List,” it will no longer be included in the development of new fragrances, and our Fragrance Scientists work diligently to remove the material from affected fragrances as quickly as possible. If you are concerned about a specific material on the “Disallowed Materials List,” please contact us to obtain additional information.
OUR FRAGRANCE PALETTE
DOWNLOAD A PDF
DISALLOWED MATERIALS LIST
DOWNLOAD A PDF
Related Articles
Formula Safe For The Environment
Our consumers care about the environmental impact of the products they buy. And so do we.
READ MORE
We Care About Animals

We use two parallel approaches to avoid animal testing: The first is to reduce the number of safety tests required by taking advantage of previously developed knowledge as the foundation of our safety evaluation.
READ MORE
EU Fragrance Allergens

The vast majority of fragrance materials are safe for consumers to use.
READ MORE
- Home
- Fragrance Palette




